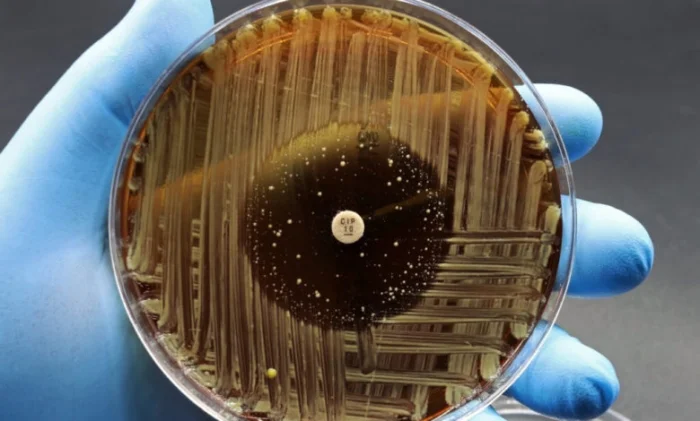
Новый класс антибиотиков макролоны: прорыв в медицине

Новый класс антибиотиков макролоны: прорыв в медицине
Знаете это чувство, когда какая-то давняя, вроде бы решённая проблема снова начинает стучаться в дверь? Примерно так обстоят дела с бактериями. Мы так долго и успешно травили их антибиотиками, что они решили играть по-крупному и превратились в супербактерий. Но, кажется, у учёных нашёлся новый, очень хитрый козырь в рукаве. Знакомьтесь — макролоны.
Эпидемия, которую мы не замечаем
Вы удивитесь, но золотая эра антибиотиков, начавшаяся в 20-х годах прошлого века, постепенно подходит к концу. Мы так увлеклись этими таблетками, что назначали их по поводу и без, а бактерии — они же живые и тоже хотят выжить. Они научились менять «замки» под нашими «ключами», уничтожать сами лекарства или просто выплевывать их обратно.
Сегодня это уже не просто страшилка из лаборатории. Это полноценный глобальный кризис. По данным ВОЗ, только в 2019 году из-за устойчивости к антибиотикам погибло около 1,27 миллиона человек. Вдумайтесь в эту цифру — это население огромного мегаполиса. И она растёт, потому что микробы эволюционируют быстрее, чем фармкомпании успевают придумывать новые формулы. Становится страшновато, правда?
Именно поэтому любая новость о прорыве в этой области звучит как гимн надежде.
Макролоны: удар дуплетом
Команда исследователей из Чикаго и Пекина решила не изобретать велосипед, а собрать два старых, но надежных механизма в один супергибрид. Они взяли макролиды (они блокируют синтез белка в бактерии) и фторхинолоны (они ломают ДНК бактерии) и соединили их в одной молекуле — макролоне.
Представьте, что вы играете в шахматы сразу на двух досках. Примерно то же самое чувствует бактерия, когда в неё попадает макролон. Ей нужно одновременно мутировать в двух разных местах, чтобы защитить и свой «завод» по производству белка, и свою «библиотеку» с ДНК.
По оценкам учёных, это усложняет жизнь бактериям в 100 миллионов раз. Шансов на то, что у них выработается устойчивость к такому комбо, просто исчезающе мало. Согласитесь, звучит как гейм-ченджер.
Не всё сразу, но всё серьёзно
Первые тесты уже показали, что макролоны работают даже при низких концентрациях. Более того, они всё ещё бьют по тем штаммам, которые уже успели стать неуязвимыми для обычных макролидов. То есть старые знакомые лекарства уже не работают, а новый гибрид — запросто.
Но, как всегда в науке, от лабораторного успеха до аптечки путь неблизкий. Учёным предстоит ещё много работы: сделать молекулу безопасной для нас с вами, наладить её массовое производство, чтобы лекарство было доступным по цене. И конечно, нужно будет продолжать следить за бактериями — а ну как и тут придумают, как обмануть систему?
Исследование, кстати, опубликовано в серьёзном журнале Nature Chemical Biology. Так что это не газетная утка, а реальный шаг вперёд. Будем надеяться, что у макролонов всё получится.